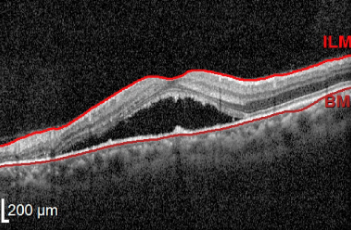
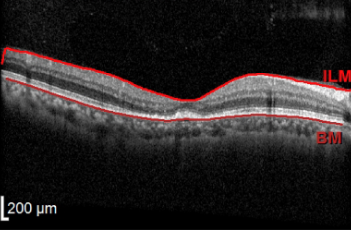

KIM’S RETINA CLINIC
중심성장액망막병증
김이태 망막 클리닉
중심성망막증이라고도 불리며 맥락막의
혈류 이상에 의해 황반에 물이차서 부종이 생기는 질환
KIM’S RETINA CLINIC
최고의 의료진이 최선을 다하는 김이태안과 입니다.
중심성장액망막병증
보통 망막과 맥락막 사이에 위치한 망막 색소상피라는 층이 맥락막에서 망막으로
물이 새는 것을 저지하는 역할이었는데, 이것이 온전하지 못해 망막에 물이 새기 때문에
망막색소상피 질환과도 관련이 있습니다.
마이크로펄스 레이저 시술 전
마이크로펄스 레이저 시술 후
중심성장액망막병증 치료와 예방
급성중심망막염은 다른 치료 없이 호전될 가능성이 높기 때문에 1~3개월 경과 관찰합니다.
중심망막병증은 과도한 스트레스를 받을 경우 발병 확률이 증가하기 때문에
충분한 수면을 취하시길 권유해 드립니다.
마이크로 펄스 레이저
빠른 회복을 원하는 환자, 여러 번 재발한 경우, 오랫동안 호전이 없는 환자를 대상으로
김이태 안과에서는 마이크로펄스 레이저를 구비하고 있어서
황반부에 안전하게 레이저 치료가 가능합니다.